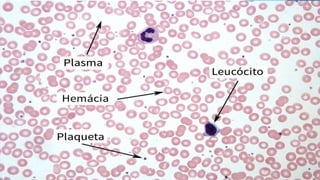
Hematopoiese aula 3.pptx

A hematopoiese é o processo de produção e maturação de células sanguíneas a partir de células-tronco pluripotentes, ocorrendo principalmente na medula óssea. O documento descreve as etapas da hematopoiese, os tipos de células sanguíneas, e a diferença entre medula óssea vermelha e amarela ao longo da vida. Além disso, explora a diferenciação das células sanguíneas, mencionando os processos específicos para cada tipo celular.